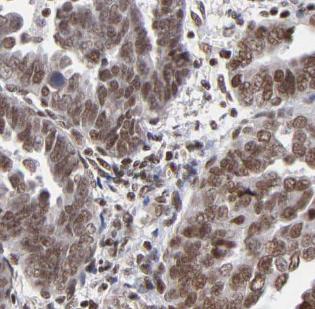
产品细节图片1

相关产品推荐更多 >
万千商家帮你免费找货
0 人在求购买到急需产品
- 详细信息
- 询价记录
- 文献和实验
- 技术资料
- 免疫原:
tumor protein p53
- 亚型:
IgG1
- 形态:
liquid
- 保存条件:
-20℃ 12月
- 克隆性:
monoclonal
- 标记物:
未标记
- 适应物种:
Human, Rat
- 保质期:
-20℃ 12月
- 抗原来源:
tumor protein p53
- 目录编号:
FNab06084
- 级别:
科研
- 库存:
100
- 供应商:
武汉菲恩生物科技有限公司
- 宿主:
Mouse
- 应用范围:
ELISA, WB, IHC
- 靶点:
TP53
- 抗体英文名:
TP53 antibody
- 抗体名:
TP53抗体
- 规格:
50ug/100ug
| 规格: | 50ug | 产品价格: | ¥1260.0 |
|---|---|---|---|
| 规格: | 100ug | 产品价格: | ¥2100.0 |

产品介绍
| 产品名称 | TP53 antibody |
| 中文名称 | TP53抗体 |
| 货号 | FNab06084 |
| 规格 | 50ug/100ug |
| 宿主 | Mouse |
| 反应种属 | Human, Rat |
| 验证应用 | ELISA, WB, IHC |
| 状态 | liquid |
| 纯化方法 | Protein A+G purification |
| 纯度 | ≥95% as determined by SDS-PAGE |
| 克隆性 | monoclonal |
| 亚型 | IgG1 |
| 免疫原 | tumor protein p53 |
| 免疫原别称 | Cellular tumor antigen p53|Antigen NY-CO-13|Phosphoprotein p53|Tumor suppressor p53|TP53|P53 |
| Uniprot ID | P04637 |
| 分子量 | 53 kDa |
| 建议稀释比例 | WB: 1:2000-1:10000; IHC: 1:500-1:2000 |
| 验证图片 | Immunohistochemistry of paraffin-embedded human ovary cancer using FNab06084(P53 antibody) at dilution of 1:500  A431 cells were subjected to SDS PAGE followed by western blot with FNab06084(P53 antibody) at dilution of 1:3000 |
| 存储 | PBS with 0.02% sodium azide and 50% glycerol pH 7.3, -20℃ for 12 months(Avoid repeated freeze / thaw cycles.) |
| 注意事项 | TP53 antibody仅供科研使用 |
菲恩生物抗体产品优势
种类齐全:有10000多种经过验证的免多抗和小鼠单抗,包括流式抗体、内参抗体、标签抗体、小分子化合物抗体、对照抗体等;
多种标记/非标记二抗:针对兔、羊、小鼠、大鼠、人等多个种属。100多种标记二抗,标记物包括HRP、Biotin、FITC、Cy3、Alexa Fluor 488、Alexa Fluor 594等,通过了蛋白质印迹、免疫荧光、免疫组织化学、流式细胞术和ELISA等免疫学相关应用的充分验证,可满足各种实验需求;
验证过多种实验:ELISA、WB、IHC、IF、IP、FC等应用,并进行了广泛的物种交叉实验。
风险提示:丁香通仅作为第三方平台,为商家信息发布提供平台空间。用户咨询产品时请注意保护个人信息及财产安全,合理判断,谨慎选购商品,商家和用户对交易行为负责。对于医疗器械类产品,请先查证核实企业经营资质和医疗器械产品注册证情况。
- 作者
- 内容
- 询问日期
 文献和实验
文献和实验Science:直击肿瘤命门,Shibin Zhou 等开发靶向 TP53 突变的双特异性抗体
对突变型 p53 的药物被批准用于治疗含有这些突变的肿瘤患者。 2021 年 3 月 1 日,来自美国的 Bert Vogelstein, Sandra B. Gabelli 和 Shibin Zhou 团队研制出了一种靶向 TP53 突变基因的双特异性单链抗体(bispecific single-chain diabody,scDb)。这种双特异性抗体在体外和小鼠体内都能有效识别呈递新抗原的癌细胞,并激活 T 细胞,发挥抗肿瘤效应。 从理论上讲,这种双特异性抗体可以用来针对含有传统方法难以瞄准
免疫细胞可识别并杀伤有害的靶细胞(如突发性肿瘤细胞),是人体宿主防御机制的一个重要组成部分。抗体依赖性细胞介导的细胞毒性 (ADCC) 和 T 细胞杀伤是细胞介导的免疫应答的两种机制,其中的每个过程都涉及刺激免疫细胞亚群(例如,自然杀伤 (NK) 细胞或细胞毒性 T 淋巴细胞 (CTL)),使它们主动裂解靶细胞。 近期,约翰霍普金斯大学医学院的研究人员在Science期刊发表研究成果[1]。他们发现了靶向TP53突变的新抗原,筛选出一种抗体片段(H2-scFv)特异性识别灭活的肿瘤
®应用领域 Incucyte®应用方向 在此,我们甄选出五篇使用Incucyte®的高引CNS文章,详细介绍实时活细胞分析技术的典型应用。 1. Science:免疫细胞杀伤 应用领域:肿瘤学 视频来源:Han-Chuang Hsiue et al. Science 2021, 05, 371(6533) 约翰霍普金斯大学的Shibin Zhou等人[1]开发出一种靶向TP53突变基因的双特异性单链抗体H2-scDb。采用Incucyte®的NucLight
 技术资料
技术资料暂无技术资料 索取技术资料








